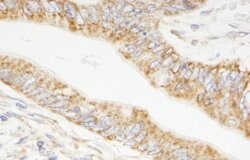
TRIM3/BERP Rabbit anti-Human, Polyclonal, Bethyl Laboratories 100 &mu;L;

Learn More
TRIM3/BERP Rabbit anti-Human, Polyclonal, Bethyl Laboratories
Rabbit Polyclonal Antibody
Supplier: Bethyl Laboratories, Inc A301207A

Description
The recommended shelf life for this product is 1 year from date of receipt. Application Note: For IHC, epitope retrieval with citrate buffer pH 6.0 is recommended for FFPE tissue sections. Based on 100% sequence identity, this antibody is predicted to react with Mouse and Rat
The protein encoded by this gene is a member of the tripartite motif family, also called the ′RING-B-box-coiled-coil′ subgroup of RING finger proteins. The TRIM motif includes three zinc-binding domains, a RING, a B-box type 1 and a B-box type 2, and a coiled-coil region. This protein localizes to cytoplasmic filaments. It is similar to a rat protein which is a specific partner for the tail domain of myosin V, a class of myosins which are involved in the targeted transport of organelles. The rat protein can also interact with alpha-actinin-4. Thus it is suggested that this human protein may play a role in myosin V-mediated cargo transport. Alternatively spliced transcript variants encoding the same isoform have been identified.Specifications
| TRIM3/BERP | |
| Polyclonal | |
| Unconjugated | |
| TRIM3 | |
| TRIM3; BERP; RNF22; TRIM3; tripartite motif-containing 3; HAC1; RNF97; ring finger protein 22; brain expressed ring finger; tripartite motif protein TRIM3; FLJ16135 | |
| Rabbit | |
| Antigen affinity chromatography | |
| RUO | |
| 10612 | |
| 4° C | |
| Liquid |
| Immunohistochemistry, Immunoprecipitation | |
| 1 mg/ml | |
| phosphate, tris citrate with 0.09% sodium azide; pH 7-8 | |
| O75382 | |
| TRIM3 | |
| Between 1 and 50 | |
| 100 μL | |
| Primary | |
| Human | |
| Antibody | |
| IgG |
The Fisher Scientific Encompass Program offers items which are not part of our distribution portfolio. These products typically do not have pictures or detailed descriptions. However, we are committed to improving your shopping experience. Please use the form below to provide feedback related to the content on this product.